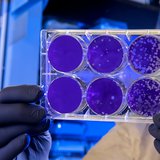

Kineski naučnici nedavno su predstavili inovativnu vrstu cigle za koju se nadaju da će se u bliskoj budućnosti koristiti za izgradnju prve baze i useljivih kuća na površini Meseca.
Kina ima velike planove kada je u pitanju kolonizacija Meseca. Ranije ove godine, postala je prva zemlja koja je spustila sondu na tamnu stranu Meseca i vratila je sa vrednim uzorcima zemlje, a čini se da je postavljanje ljudi na Mesec sledeći logičan korak. Međutim, azijski gigant već planira dan kada ćemo moći da gradimo baze i druge zgrade na prirodnom satelitu Zemlje, i u tom cilju je razvio genijalan tip cigle dizajniran da izdrži i fizički pritisak i visok nivo zračenja od sunca. Takozvane cigle sa mesečevom zemljom biće poslate na Mesec na testiranje do kraja sledeće godine.

Foto: Printscreen YouTube/CCTV中文
Opeke od Mesečevog tla razvio je tim stručnjaka u Nacionalnom centru za inovacije digitalne građevinske tehnologije Univerziteta nauke i tehnologije Huazhong. Imaju strukturu ureza i čepa kako bi se lakše sastavili i namenjeni su da simuliraju sastav mesečevog tla. Međutim, stručnjaci tvrde da je neophodno da cigle od mesečevog tla imaju određena svojstva.

Foto: Printscreen YouTube/CCTV中文
Na primer, čvrstoća na pritisak lunarnih cigli je više od 3 puta veća od obične crvene cigle i betonske cigle, što je ekvivalentno tome da može da izdrži težinu veću od jedne tone po kvadratnom centimetru. Takođe, pošto je Mesec vakuumsko okruženje i postoji velika količina kosmičkog zračenja, istraživači žele da shvate da li cigle lunarnog tla mogu da izdrže efekte kosmičkog zračenja na Mesecu.
Prve cigle na svetu sa mesečevom zemljom biće poslate na kinesku svemirsku stanicu na teretnom svemirskom brodu Tianzhou-8. Oni će biti opsežno testirani do kraja sledeće godine, kada se kineski naučnici nadaju da će znati da li su nove cigle pogodne za lunarni razvoj.
IZVOR: YT / CCTV中文
Autor: REDPORTAL.RS